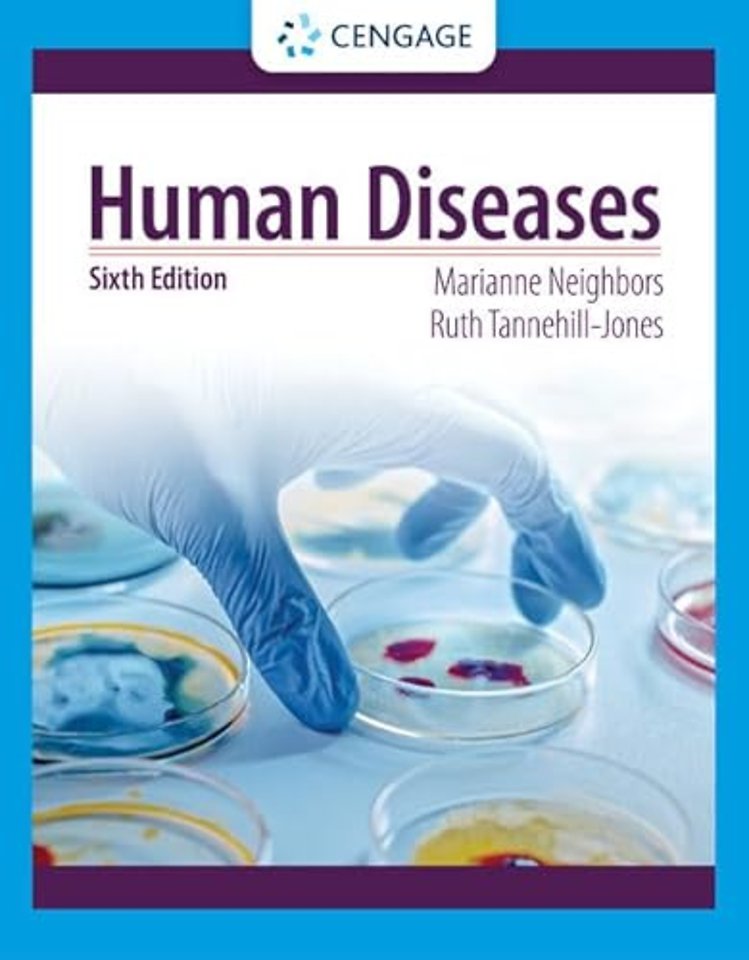
Human Diseases

Marianne Neighbors,
Marianne (University of Arkansas) Neighbors,
Ruth Tannehill-Jones,
Ruth (Mercy Health System, NWA, St. Mary's Hospital) Tannehill-Jones
e.a.
Cengage Learning, Inc
e druk, 2022
9780357618042
Human Diseases
Specificaties
Paperback, 624 blz.
|
EN
Cengage Learning, Inc |
e druk, 2022
ISBN13: 9780357618042
Rubricering
Levertijd ongeveer 7 werkdagen